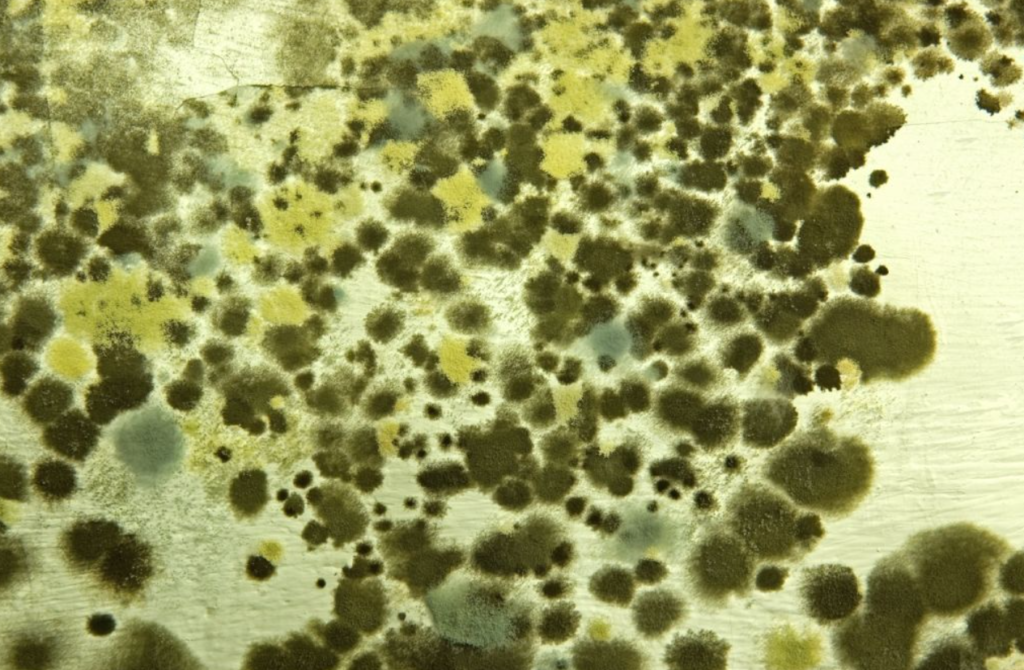
San Diego Mold Testing for Green Molds

San Diego Mold Testing for Green Molds
Mold occurs in more than just one form and color; that is why we’re often confused about Mold’s presence. However, it has certain things in common, i.e., they all grow in most environments and feed off on organic matter, but what you must be concerned about is that Mold’s presence in your living space is always dangerous for you and your children’s health. Green Mold is the most common color that Mold mostly appears in, so you must have thought about whether it is dangerous or not. In this blog, we have discussed the fundamental things you must know about the Green Mold that appears in your homes. The information is provided to you by a San Diego Mold Testing company named Smart Dry Restoration; please feel free to contact us about Mold’s issues at your residence.
Mold occurs in more than just one form and color; that is why we’re often confused about Mold’s presence. However, it has certain things in common, i.e., they all grow in most environments and feed off on organic matter, but what you must be concerned about is that Mold’s presence in your living space is always dangerous for you and your children’s health. Green Mold is the most common color that Mold mostly appears in, so you must have thought about whether it is dangerous or not. In this blog, we have discussed the fundamental things you must know about the Green Mold that appears in your homes. The information is provided to you by a San Diego Mold Testing company named Smart Dry Restoration; please feel free to contact us about Mold’s issues at your residence.
What is green Mold?
A broad category of various species of fungi is termed as green Mold. So fungus is a green layer in color and is usually soft, fuzzy, or chalky in form. You must have noticed a green layer of fungus on fruits, bread, or any other food if kept for a long while. But food is not the only habitat for Mold to grow on or feed off. Mold can also feed off on organic matter; all Mold needs is a consistently moist environment to survive in.
The most common forms in which green Mold appears are Cladosporium, Aspergillus, and Penicillium.
- Cladosporium is olive green in color. It appears on plants mainly, but their habitat is not only limited to plants because they also grow on your household surfaces like ceilings, cabinet doors, and rugs and feed on them if they are provided with a moist environment.
- Aspergillus is the kind of Green Mold that usually appears on rotten food like fruits or bread. Aspergillus also grows in moist environments like basements and bathrooms.
- Penicillium is bluish-green. They emit mycotoxins, which are hazardous for human beings and animals alike. Such a Mold usually occurs in cold and severely moist environments like soil. Please know that they can also appear on wet items at your home.
Such Molds can appear in other colors like pure blue or pure black; that is why it is essential to test the kind of Mold you’re dealing with at your house to know whether it is harmful or not.
Is green Mold dangerous?
It is a widespread belief that black Mold is the only type of harmful Mold, entirely a wrong concept. Green Mold is as dangerous as black Mold as it can cause some severe health issues for you and your children or pets.
The fact that you must know all kinds of Molds, regardless of the color or form that they appear in, are extremely hazardous for your health. If you are regularly exposed to Mold may severely damage your respiratory system and cause you issues like asthma attacks or allergens. So whenever you encounter Green Mold, you must undoubtedly get rid of it before it causes you health issues.
For expert mold removal, contact the Smart Dry Restoration San Diego, CA
It is vital to call experts who provide services for San Diego Mold Testing and is found at our Smart Dry Restoration Company. Our experts will examine your belongings. Call us immediately on our emergency line service, (858)-433-5100 if you need restoration services and request for emergency services on our helpline so we can directly come over. We are available 24/7 for any such problem. To learn more, contact us today. Our team of Smart Dry Restoration San Diego, CA experts is always ready to speak with you. You can also go through our website for other related services you can avail of in the future.
Business Info
- Monday–Friday24hrs
- Saturday24hrs
- Sunday24hrs
8910 Activity Rd. Ste A
San Diego, CA 92126

